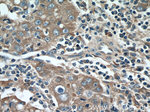
EDIL3 Antibody in Immunohistochemistry (Paraffin) (IHC (P))

Search
Proteintech
EDIL3 Polyclonal Antibody
{{$productOrderCtrl.translations['antibody.pdp.commerceCard.promotion.promotions']}}
{{$productOrderCtrl.translations['antibody.pdp.commerceCard.promotion.viewpromo']}}
{{$productOrderCtrl.translations['antibody.pdp.commerceCard.promotion.promocode']}}: {{promo.promoCode}} {{promo.promoTitle}} {{promo.promoDescription}}. {{$productOrderCtrl.translations['antibody.pdp.commerceCard.promotion.learnmore']}}
产品信息
12580-1-AP
种属反应
已发表种属
宿主/亚型
分类
类型
抗原
偶联物
形式
浓度
规格
纯化类型
保存液
内含物
保存条件
运输条件
产品详细信息
Immunogen sequence: GGICTDLVA NYSCECPGEF MGRNCQYKCS GPLGIEGGII SNQQITASST HRALFGLQKW YPYYARLNKK GLINAWTAAE NDRWPWIQIN LQRKMRVTGV ITQGAKRIGS PEYIKSYKIA YSNDGKTWAM YKVKGTNEDM VFRGNIDNNT PYANSFTPPI KAQYVRLYPQ VCRRHCTLRM ELLGCELSGC SEPLGMKSGH IQDYQITASS IFRTLNMDMF TWEPRKARLD KQGKVNAWTS GHNDQSQWLQ VDLLVPTKVT GIITQGAKDF GHVQFVGSYK LAYSNDGEHW TVYQDEKQRK DKVFQGNFDN DTHRKNVIDP PIYARHIRIL PWSWYGRITL RSELLGCTEE E (131-480 aa encoded by BC030828)
靶标信息
Del-1 is an integrin ligand that is expressed by endothelial cells during embryological vascular development. It promotes adhesion of endothelial cells through an interaction with the alpha-v/beta-3 integrin receptor. Del-1 plays a vital role in mediating angiogenesis.
仅用于科研。不用于诊断过程。未经明确授权不得转售。
生物信息学
蛋白别名: developmental endothelial locus-1; Developmentally-regulated endothelial cell locus 1 protein; EGF-like repeat and discoidin I-like domain-containing protein 3; EGF-like repeats and discoidin I-like domains 3; Integrin-binding protein DEL1; unnamed protein product
基因别名: Del-1; DEL1; EDIL3
UniProt ID: (Human) O43854, (Mouse) O35474
Entrez Gene ID: (Human) 10085, (Mouse) 13612, (Rat) 688400